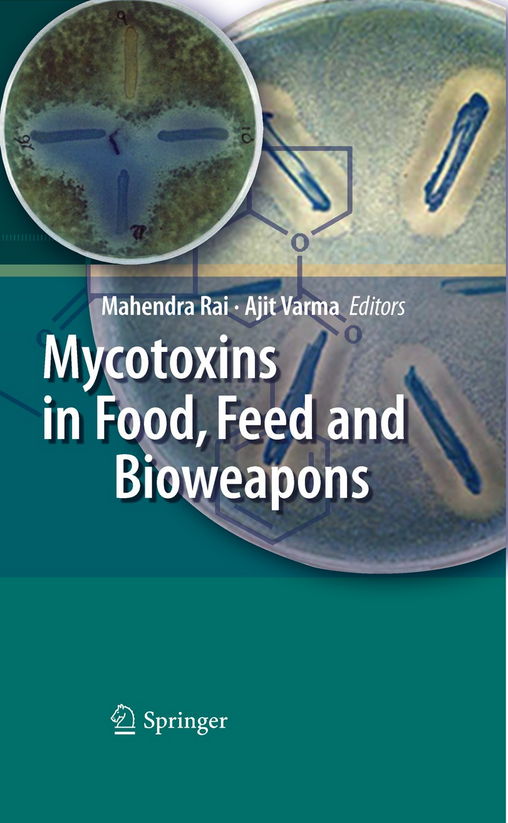

Newly released
This book is new and will be uploaded as soon as it becomes available to us and if we secure the necessary publishing rights.
Mycotoxins in Food, Feed and Bioweapons PDF - Mahendra Rai
Mahendra Rai • Biology
(0)
Quate
Review
Save
Share
Book Description
Mycotoxins are made by different biosynthetic pathways, and they have an extremely wide range of pharmacological effects. This book will update readers on several cutting-edge aspects of mycotoxin research, including topics such as: new analytical methods for detection; the adoption of an ancient Mexican process for detoxification of aflatoxins; mycotoxin management in Ireland, Lithuania and South America; mycotoxin reduction through plant breeding and integrated management practices; and natural aflatoxin inhibitors from medicinal plants. Further contributions examine ochratoxins, selected trichothecenes, zearalenone, and aflatoxin-like gene clusters, as well as sclerotial development in Aspergillus flavus and A. parasiticus. Of particular interest are the chapters on the potential use of mycotoxins as bioweapons. This book will stimulate new thinking on the need to develop therapeutic as well as preventative interventions to reduce the toxicological threat of mycotoxins.
Mahendra Rai
Dr. Mahendra Rai is a Senior Professor and UGC-Basic Science Research Faculty at the Department of Biotechnology, Sant Gadge Baba Amravati University, Amravati, Maharashtra, India.
Professor Rai has published more than 400 research papers in Indian and foreign peer reviewedjournals, 50 books in association with some reputed publishers such as Springer, Elsevier, CRC, Taylor and Francis and Scientific Publisher, and more than 102 popular articles. Professor Rai’s research has provided seven patents. He is a member of several scientific societies. His area of expertise includes microbial biotechnology and nanobiotechnology. Currently, the main research interest of his group is biogenic synthesis of metal nanoparticles particularly using fungi and their applications as nanoantimicrobials against multidrug resistance microbes. He believes that silver nanoparticles are the new generation of antimicrobials because of their potential against human pathogenic microbes and also for possibility of solving the problem of drug resistance by using a combination of the silver nanoparticles with different antibiotics. His research is highly interdisciplinary and combines microbial biotechnology with nanotechnology. He aims to focus on understanding the mechanism of biological synthesis of metal nanoparticles by microbes and also the toxicity issues. Recently, he has been interested in using of nanoparticles for the management of plant pathogens.
He has received several prestigious awards, including the father T.A. Mathias award (1989) from the All India Association for Christian Higher Education, and the Medini Award for book on Herbal Medicines by the Government of India. He also visited Brazil under TWAS-UNESCO Associateship (2002, Italy), as a Visiting Scientist at the Department of Bioenergetics, University of Geneva, Switzerland (2004), under Hungarian Scholarship to visit the Department of Plant Protection, Debrecen University, Hungary (2006, 2008, 2015), as a Visiting Professor, Department of Microbiology, Nicolaus Copernicus University, Torun Poland (2012, 2014, 2015); also as a Visiting Scientist, Biological Chemistry Laboratory, State University of Campinas under Indo-Brazil programme (2009-2012), and in 2013 under FAPESP programme. In 2015 (October- November), he was a visiting scientist at Nanotechnology Center, VSB Technological University of Ostrava.
Dr. Rai serves as a referee for 20 international journals and is a member of the editorial board of ten national and international journals. He has approximately three decades of teaching and research experience.
Dr. Rai has numerous international collaborations, including Argentina, Hungary, Switzerland, Italy, Germany, Brazil and USA in microbial biotechnology and nanobiotechnology.
Book Currently Unavailable
This book is currently unavailable for publication. We obtained it under a Creative Commons license, but the author or publisher has not granted permission to publish it.
Rate Now
5 Stars
4 Stars
3 Stars
2 Stars
1 Stars
Mycotoxins in Food, Feed and Bioweapons Quotes
Top Rated
Latest
Quate
Be the first to leave a quote and earn 10 points
instead of 3
Comments
Be the first to leave a comment and earn 5 points
instead of 3